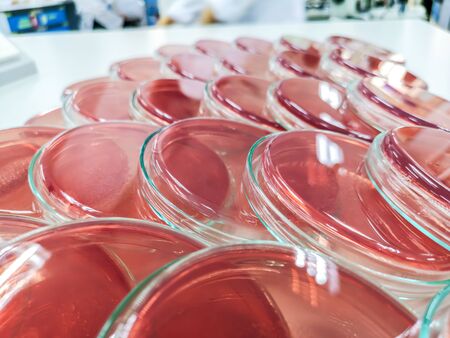
MacConkey agarの写真素材

写真素材 - MacConkey agar
キーワード
- agar
- agars
- analysis
- background
- bacteria
- bacterial
- bacteriology
- bacterium
- biology
- biotechnology
- closeup
- colony
- color
- culture
- diagnosis
- disease
- dish
- experiment
- food
- growth
- health
- hospital
- identification
- isolated
- isolation
- lab
- laboratory
- macconkey
- macconkey agar
- media
- media culture
- medical
- medicine
- medium
- micro
- microbiology
- microorganism
- pathogen
- petri dish
- pink
- pink agar
- plate
- red
- research
- safety
- science
- scientific
- sterile
- test
- white
類似作品
Rainbow sphere ...
Background saus...
Petri dishes co...
Portrait of you...
petri dishes wi...
many empty whit...
Egg halves with...
Backgrounds of ...
line of white r...
Broken and smas...
Fried eggs cook...
A transparent b...
Close-up of mil...
Moon jellyfish,...
Underwater view...
An overhead, to...
A collection of...
This beautiful ...
Close-up view o...
Bacterial colon...
3d illustration...
Extreme close-u...
Freshly cooked ...
Glass Ball
Closeup Multime...
A plastic cup o...
hamburger bread...
Date fruits on ...
Close-up of red...
Glass of cold w...
Vibrant red and...
Milan, Italy - ...
A minimalist 3D...
Close-up photog...
close-up of cry...
Enjoying a swee...
Egg yolk
Pancakes with m...
a lot of variet...
Red jelly cake ...
pink jelly in t...
Abstract black ...
Bacterial cultu...
Plastic polluti...
transparent gla...
Meat, square ha...
Close-up of cla...
microbial cultu...
Red jelly puddi...